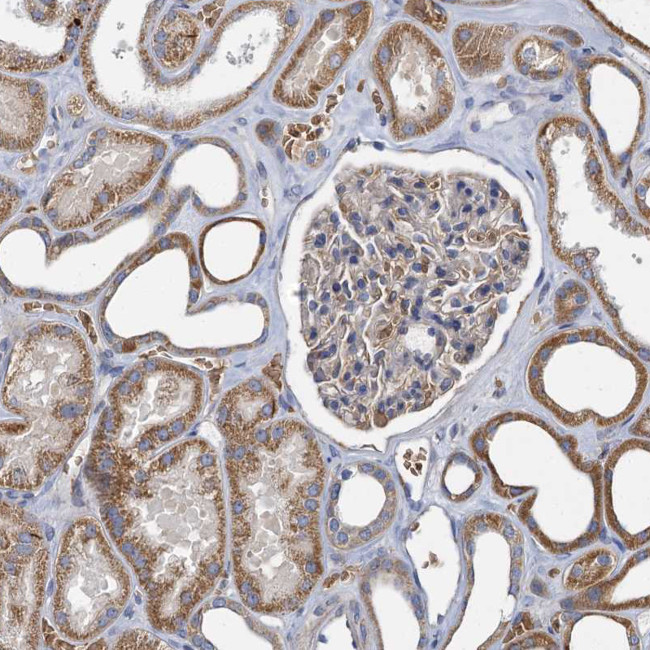
BCS1L Antibody in Immunohistochemistry (Paraffin) (IHC (P))

Search
Invitrogen
BCS1L Polyclonal Antibody
{{$productOrderCtrl.translations['antibody.pdp.commerceCard.promotion.promotions']}}
{{$productOrderCtrl.translations['antibody.pdp.commerceCard.promotion.viewpromo']}}
{{$productOrderCtrl.translations['antibody.pdp.commerceCard.promotion.promocode']}}: {{promo.promoCode}} {{promo.promoTitle}} {{promo.promoDescription}}. {{$productOrderCtrl.translations['antibody.pdp.commerceCard.promotion.learnmore']}}
产品信息
PA5-58066
种属反应
宿主/亚型
分类
类型
抗原
偶联物
形式
浓度
规格
纯化类型
保存液
内含物
保存条件
运输条件
RRID
产品详细信息
Immunogen sequence: RVDLKEYVGY CSHWQLTQMF QRFYPGQAPS LAENFAEHVL RATNQISPAQ VQGYFMLYKN DPVGAIHNAE S
Highest antigen sequence identity to the following orthologs: Mouse - 92%, Rat - 94%.
靶标信息
This gene encodes a homolog of the S. cerevisiae bcs1 protein which is involved in the assembly of complex III of the mitochondrial respiratory chain. The encoded protein does not contain a mitochondrial targeting sequence but experimental studies confirm that it is imported into mitochondria. Mutations in this gene are associated with mitochondrial complex III deficiency and the GRACILE syndrome. Five alternatively spliced transcripts encoding the same protein have been described.
仅用于科研。不用于诊断过程。未经明确授权不得转售。
篇参考文献 (0)
生物信息学
蛋白别名: BC1 (ubiquinol-cytochrome c reductase) synthesis-like; BCS1-like (S. cerevisiae) isoform BCS1L_1; BCS1-like (S. cerevisiae) isoform BCS1L_2; BCS1-like protein; h-BCS1; Mitochondrial chaperone BCS1; mitochondrial complex III assembly; mitochondrial protein; unnamed protein product
基因别名: BCS; BCS1; BCS1L; BJS; FLNMS; GRACILE; h-BCS; h-BCS1; Hs.6719; MC3DN1; PTD
UniProt ID: (Human) Q9Y276
Entrez Gene ID: (Human) 617